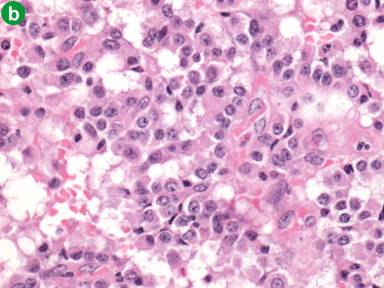
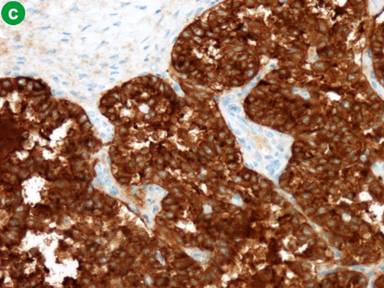
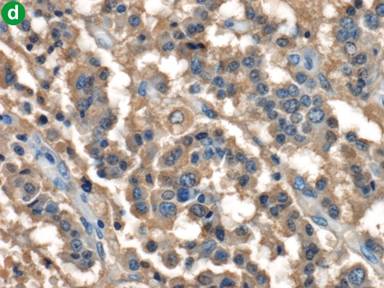

CASE REPORT
JOP. J Pancreas (Online) 2013 Sep 10; 14(5):510-514.
Pancreatic Glucagonoma Metastasising to the Right Ovary Five Years after Initial Surgery: A Case Report
David Graham Watt1, Sanjay Pandanaboyana4, Charles Simon Herrington2, Iain S Tait3
1General Surgery, 2Department of Pathology, and 3Hepatobiliary and Pancreatic Surgery, Ninewells Hospital and Medical School. Dundee, Scotland, United Kingdom. 4Hepatobiliary and Transplant Surgery, St James University Hospital. Leeds, West Yorkshire, United Kingdom
ABSTRACT
Context Glucagonomas of the pancreas are neuroendocrine tumours (NETs) that arise from well-differentiated neuroendocrine cells within the pancreatic islets. They are considered to be aggressive NETs and often have metastases at initial presentation. In contrast localised glucagonoma without metastatic spread may have prolonged disease free survival with radical resectional surgery. Case report The authors present a case of a glucagonoma that initially presented with classical necrolytic migratory erythema and a large solitary mass in the body and tail of the pancreas that was surgically resected. Five years after surgery the patient presented with increased serum glucagon levels and a mass in the right ovary. Pathology of the resected ovary after oophorectomy identified this as an isolated metastatic glucagonoma. Conclusion Glucagonoma is a rare pancreatic NET that has significant malignant potential. This is the first case of a pancreatic glucagonoma metastasising to the ovary 5 years after radical distal pancreatosplenectomy.
INTRODUCTION
Pancreatic neuroendocrine tumours (NETs) are rare tumours of the pancreatic islet cells. NETs arise from mature endocrine cells in the pancreas or multi-potent stem cells and express chromogranin A, synaptophysin and/or neuron-specific enolase. NETs may also secrete neuropeptides that may cause clinical symptoms or syndromes, such as Zollinger-Ellison syndrome (gastrinoma) or necrolytic migratory erythema (glucagonoma).
There are various types of NETs including insulinomas, gastrinomas, VIPomas, carcinoid tumours and glucagonomas [1]. Surgery is the only curative treatment for those tumours that are localised at presentation [2]. A glucagonoma is derived from the alpha cells of the pancreas. As the name suggests, these cells are usually responsible for the production of glucagon in the body. Glucagonoma was first described by Becker in 1942 [3] and has an incidence of 1 in 20,000,000 per year [4].
The authors present a case of pancreatic glucagonoma localised to the body and tail of the pancreas that was resected in 2007 by laparoscopic distal pancreatosplenectomy. In February 2012 (5 years later) the patient presented with raised glucagon levels and a mass in the pelvis on cross-sectional imaging. At laparoscopy a large solitary right ovarian mass was identified and resected. Pathological examination of the ovary identified this as metastatic NET consistent with glucagonoma. This is the first reported case of isolated metastatic glucagonoma in the ovary, five years after resection of a primary pancreatic glucagonoma.
CASE REPORT
A 62-year-old lady presented to the dermatology clinic with a 36-month history of dermatosis affecting the lower legs, axillae, groins and sub-mammary regions (Figures 1 and 2). The rash was intermittent in nature, non-pruritic, associated with hair thinning, and had not responded to topical treatments. Skin patch testing was negative and therefore skin biopsies were taken. These biopsies showed necrolytic migratory erythema. Blood tests were ordered to include minerals and electrolytes, chromogranin A and glucagon levels. Zinc levels were found to be low, N-terminal glucagon raised at 965 ng/L (reference range: 0-250 ng/L) and c-terminal glucagon raised at 580 ng/L (reference range: 0-150 ng/L). The biochemical diagnosis of a pancreatic glucagonoma was confirmed and cross-sectional imaging demonstrated a 5 cm mass lesion in the body and tail of the pancreas with no evidence of nodal disease or other metastatic spread (Figure 3).

|
Figure 1. Dermatosis affecting the axilla that was shown to be necrolytic migratory erythema following skin biopsy. |

|
Figure 2. Dermatosis affecting the lower legs that was shown to be necrolytic migratory erythema following skin biopsy. |

|
Figure 3. Cross sectional CT scanning showing a mass in the tail of the pancreas (red arrow). |
The patient underwent a laparoscopic radical antegrade pancreatosplenectomy in February 2007 and the patient made an excellent post-operative recovery. Pathology confirmed this to be a neuroendocrine tumour with evidence of glucagon production, staged as pT2, pN0, pMx. Histology demonstrated a uniform appearance with islands and trabeculae of cells with pink cytoplasm and open nuclei. These features were in keeping with a glucagonoma that was completely excised (R0). A baseline early post-operative octreotide scan at 3 months showed no evidence of occult metastatic disease. Genetics showed no evidence of mutation in the MEN 1 gene and, following surgery the necrolytic migratory erythema rash rapidly resolved. The patient was placed on a surveillance programme of 6 monthly monitoring of serum glucagon levels and annual CT scan of chest and abdomen.
Five years after laparoscopic distal pancreatosplenectomy, surveillance glucagon levels showed a slight elevation whilst the patient remained otherwise well and asymptomatic. CT scanning showed a suspicious lesion in the distal small bowel, deep in the pelvis, with mucosal thickening and hyper-enhancement. This was thought to be a primary neuroendocrine tumour of the small bowel (Figure 4), as this would be regarded as an unusual site for recurrence of a primary pancreatic NET.

|
Figure 4. Cross sectional CT scanning demonstrating an abnormality in the pelvis, thought to be dilated terminal ileum with mucosal thickening and hyper-enhancement (red arrow). |
As there was uncertainty of the nature of the mass lesion in the distal small bowel, which was considered to be a most unusual site for glucagonoma recurrence, a laparoscopy was performed. At laparoscopy, the entire small bowel was examined and no lesion identified. However, the right ovary looked markedly abnormal and contained a large tumour, with no evidence of peritoneal disease, and no evidence of liver metastases. A laparoscopic right oophorectomy was performed and the patient made a good post-operative recovery and was discharged home.
Macroscopically, the ovary was enlarged, measuring 50x40x55 mm, and weighed 55 g. It had a nodular appearance with an intact outer capsule. On sectioning, the ovary contained a multilocular cystic lesion, the largest cystic space measuring 20 mm in diameter. The non-cystic areas of the ovary had a yellow cut surface. Microscopic analysis demonstrated tumour cells with monomorphic nuclei and pale pink cytoplasm arranged predominantly in glandular and trabecular structures (Figure 5ab). Immunohistochemistry showed diffuse expression by tumour cells of cytokeratin 18 and synaptophysin (Figure 5c), with focal expression of chromogranin and cytokeratin 19, and cytoplasmic positivity for glucagon (Figure 5d). Overall the appearances indicated a neuroendocrine tumour, and were compatible with an ovarian metastasis from the original glucagonoma. The patient remains well at 16 months follow-up after oophorectomy, and with no evidence of any further metastatic disease (now more than 6 years after laparoscopic resection of the primary glucagonoma).

|
Figure 5. Photo microscopy from the resected ovarian specimen. a. This panel shows a low power view stained with haematoxylin and eosin (H&E; total magnification x40). The tumour is shown with the black arrow and ovarian cortex with yellow arrow. b. This panel is a high power view of the tumour cells, confirming the neuroendocrine appearance (H&E; total magnification x200). c. Section stained with synaptophysin which is a marker of neuroendocrine differentiation (total magnification x200). d. Section of tumour stained with glucagon, in keeping with metastatic glucagonoma (total magnification x200). |
DISCUSSION
The first pancreatic “hormone-producing tumours” were described by Wilder et al. in 1927, when he described a patient with a metastatic pancreatic tumour and hypoglycaemia [1]. Later, the Zollinger-Ellison syndrome and glucagonoma syndrome were described [1]. Glucagonomas more commonly affect women aged 40-60-year-old [4, 5]. They are typically slow growing and are located in the body and tail of the pancreas in more than 50% of cases [1, 4]. Patients often present with a typical para-neoplastic syndrome (glucagonoma syndrome) characterised by a specific dermatitis (necrolytic migratory erythema), glucose intolerance, weight loss and anaemia [1, 3, 4]. Other associated symptoms may include gastrointestinal disturbance, deep venous thrombosis and stomatitis. Often the biggest clue to the diagnosis is the distinctive rash of necrolytic migratory erythema [6]. These clinical features are due to the effects of excess glucagon (which causes increased glycogenolysis, gluconeogenesis, lipolysis and insulin secretion [1]). Glucagon also inhibits pancreatic and gastric secretion and reduces gut motility [1, 3].
Patients with glucagonoma of the pancreas with no evidence of metastases at presentation have a chance of cure with complete surgical resection of the tumour. This is usually in the form of a radical distal pancreatectomy [2] for tumours in the body and tail of the pancreas. Whipple’s pancreaticoduodenectomy may be performed for tumours in the head of the pancreas.
Radical antegrade pancreatosplenectomy may be performed laparoscopically (as in this patient), with recent studies reporting comparable oncological outcomes to open surgery [7, 8, 9].
A recent review by Jusoh and Ammori [10] and a recent meta-analysis by Venkat et al. [11] analysed 11 and 18 studies respectively, comparing laparoscopic and open distal pancreatectomies. They found that laparoscopic distal pancreatectomy is associated with lower blood loss and reduced hospital stay. Laparoscopic distal pancreatosplenectomy also has a lower risk of post-operative complications and wound infections and does not have a significantly longer operating time [11]. From an oncological point of view, margin positivity was also comparable with the laparoscopic technique when compared to the open technique [11]. Our case further demonstrates that laparoscopic surgery is safe and effective for treating neuroendocrine tumours of the pancreas, and curative resection can be achieved with good post-operative outcomes.
Pancreatic NETs usually spread to the liver, lungs and peritoneum [1, 2, 3, 4, 5], and there are currently no reported cases of primary neuroendocrine tumours of the pancreas metastasizing to the ovaries. The exact mechanism of spread of intra-abdominal tumours to the ovaries is unclear. However, there are three potential theories that may explain this pattern of metastatic spread. Firstly, surface implantation of tumour remnants onto the ovary from the primary tumour site seems the most logical explanation. This is more common in situations where there is evidence of peritoneal carcinomatosis [12]. Some authors have commented on the fact that metastases are more common in the right ovary than the left. This further gives weight to the idea that spread is by surface implantation as detached tumour fragments from the primary tumour will be directed towards the right iliac fossa by the slope caused from the mesenteric attachments [12]. This same mesentery almost acts as a barrier or shield for the left ovary, providing some protection. Our patient developed a right ovarian metastasis only. However, the absence of widespread peritoneal disease and the fact that the ovarian surface often remains intact have been cited as evidence against the surface implantation theory [12]. The second hypothesis is that metastases occur via lymphatic spread. The third hypothesis is that of haematological dissemination of metastatic disease, but haematological spread of pancreatic tumours to the ovaries is very rare. If it occurs these tumours will usually involve the liver and spread via the portal vein [13].
CONCLUSION
Pancreatic glucagonoma is an extremely rare NET that is most frequently located in the body and tail of the pancreas. Primary pancreatic glucagonoma usually presents with symptoms related to a paraneoplastic syndrome and can be difficult to diagnose. Often the biggest clue to the diagnosis is a distinctive rash (necrolytic migratory erythema) that can affect the entire body. Pancreatic glucagonomas frequently have liver metastases (50-70%) at presentation and should be considered as aggressive NETs with malignant potential. This paper reports on the very unusual occurrence where a large primary pancreatic glucagonoma metastasized to the right ovary five years after the initial curative surgery, and highlights the need for long-term surveillance of patients with pancreatic NETs.
Received June 1st, 2013 – Accepted August 2nd, 2013
Key words Glucagonoma; Neoplasm Metastasis; Neuroendocrine Tumors; Ovarian Neoplasms; Pancreatic Neoplasms
Abbreviations NET: neuroendocrine tumour
Conflict of interest The authors declare no conflict of interest, and that they have not received financial support or grants in the production of this manuscript
Correspondence
Iain
S Tait
Department of General Surgery
Ninewells Hospital and Medical School
Dundee DD1 9SY
Scotland
United Kingdom
Phone: +44-1382.660.111
Fax: +44-1382.496.361
E-mail: i.z.tait@dundee.ac.uk
References
1. Oberg K. Pancreatic endocrine tumors. Semin Oncol 2010; 37:594-618. [PMID: 21167379]
2. Fernández-Cruz L, Blanco L, Cosa R, Rendón H. Is laparoscopic resection adequate in patients with neuroendocrine pancreatic tumors? World J Surg 2008; 32:904-17. [PMID: 18264824]
3. Chastain MA. The glucagonoma syndrome: a review of its features and discussion of new perspectives. Am J Med Sci 2001; 321:306-20. [PMID: 11370794]
4. Dinc B, Sahin C. Metastatic glucagonoma. Eurasian Journal of Medicine 2009; 41:70-2.
5. Akerström G, Hellman P, Hessman O, Osmak L. Surgical treatment of endocrine pancreatic tumours. Neuroendocrinology 2004; 80:62-6. [PMID: 15477720]
6. Beattie PE, Fleming CJ, Evans AT, Sheppard DG, Leese GP, Dow E, Tait IS. Glucagonoma syndrome presenting as psoriasis. QJM 2002; 95:34-5. [PMID: 12454329]
7. Song KB, Kim SC, Park JB, Kim YH, Jung YS, Kim MH, et al. Single-center experience of laparoscopic left pancreatic resection in 359 consecutive patients: changing the surgical paradigm of left pancreatic resection. Surg Endosc 2011; 25:3364-72. [PMID: 21556993]
8. Nakamura M, Kakashima H. Laparoscopic distal pancreatectomy and pancreatoduodenectomy: is it worthwhile? A meta-analysis of laparoscopic pancreatectomy. J Hepatobiliary Pancreat Sci 2013; 4:421-8. [PMID: 23224732]
9. Rosok BI, Marangos IP, Kazaryan AM et al. Single-centre experience of laparoscopic pancreatic surgery. Br J Surg 2010; 97:902-9. [PMID: 20474000]
10. Jusoh AC, Ammori BJ. Laparoscopic versus open distal pancreatectomy: a systematic review of comparative studies. Surg Endosc 2012; 26:904-13. [PMID: 22083328]
11. Venkat R, Edil BH, Schulick RD, Lidor AO, Makary MA, Wolfgang CL. Laproscopic distal pancreatectomy is associated with significantly less overall morbidity compared to the open technique: A systematic review and meta-analysis. Ann Surg 2012; 255:1048-59. [PMID: 22511003]
12. Willis RA. The Spread of Tumours in the Human Body. 3rd edition. London, England: Churchill Publishers 1934:312-7. [ISBN: 9780407399013]
13. Hibner M, Greenspan D. Ovarian metastases from the biliary tract, pancreas and liver carcinomas. CME Journal of Gynaecologic Oncology 2004; 9:5-128.